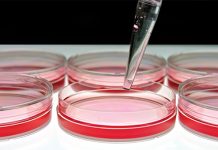
Powierzchnie w salonie kosmetycznym jako źródło zakażeń

Peeling ziołowy – wybrane zagadnienia
Choć zioła są znane i wykorzystywane w kosmetyce na wszystkich obszarach geograficznych, w zabiegach peelingu profesjonalnego stosowane są od niedawna. Głębokość ingerencji, technika wykonywania oraz efekty...
Wpływ diety na wygląd skóry
Streszczenie
Zdrowa, dobrze zbilansowana dieta i przestrzeganie zasad racjonalnego odżywiania nie tylko zapewniają organizmowi odpowiednią ilość składników odżywczych i witamin, ale również poprawiają wygląd zewnętrzny. Niedobory żywieniowe wpływają niekorzystnie na...
Rekonstrukcja piersi. Możliwości nowoczesnej kosmetologii i chirurgii
Rak piersi jest jednym z najczęściej występujących nowotworów złośliwych oraz najczęstszą przyczyną zgonów spowodowanych nowotworem u kobiet na całym świecie. Dla wielu rozpoznanie choroby brzmi jak...
Powierzchnie w salonie kosmetycznym jako źródło zakażeń
Streszczenie
W salonie kosmetycznym, oprócz narzędzi i rąk personelu, również powierzchnie mogą stanowić źródło zakażeń i zagrożenie dla klientów oraz osób pracujących w zakładzie. Powierzchnie w salonach kosmetycznych i fryzjerskich...
Postępowanie fizjoterapeutyczne w leczeniu blizn
Streszczenie
Blizny to problem zdrowotny i estetyczny, który dotyka ludzi w każdym wieku i obojga płci. W zależności od rodzaju blizny stosuje się różne terapie – chirurgiczne lub...
Kosmetyki wyszczuplające – skuteczne działanie czy marketing?
Streszczenie
Kosmetyki wyszczuplające należą do najczęściej i najchętniej kupowanych produktów do pielęgnacji ciała. Jest to spowodowane nie tylko powszechnym dążeniem do osiągnięcia szczupłej sylwetki, ale także działaniami marketingowymi firm kosmetycznych,...
Surowce roślinne w kosmetyce – fitokosmetyki
Streszczenie
Fitokosmetyki to kosmetyki wytwarzane na bazie łagodnych dla skóry surowców roślinnych, nieposiadających w swoim składzie substancji toksycznych. Substancje czynne w fitokosmetykach to: antybiotyki, azuleny, aminy, pektyny, saponiny, flawonoidy, oleje...
Łuszczyca skóry – współczesne możliwości terapii
Streszczenie
Łuszczyca jest przewlekłą chorobą o nawrotowym przebiegu. Na wystąpienie objawów choroby ma wpływ wiele czynników wyzwalających. Schorzenie może ulegać ograniczeniu samoistnie lub po zastosowaniu odpowiedniego leczenia. Współczesna medycyna oferuje szereg...